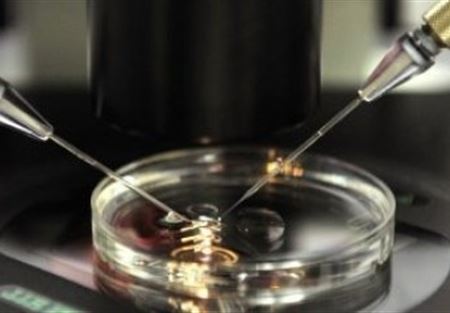

توصّل باحثون إسبان إلى إنتاج سائل منوي من خلايا جلدية، وهو وإن كان لا يؤدي إلى تخصيب البويضات الأنثوية، إلا أنه يشكل قفزةً كبيرة في مجال البحث عن علاجات للعقم.
ومع أن كثيرين يلجؤون إلى استخدام سائل منوي أو بويضات من متبرعين للإنجاب، إلا أن "الكل يفضلون أن يكون أولادهم حاملين لجيناتهم"، بحسب ما قال كارلوس سيمون المدير العلمي لمعهد العقم في فالنسيا لوكالة الأنباء الفرنسية.
وأجرى هذه الأبحاث معهد فالنسيا بالتعاون مع جامعة ستانفورد الأميركية في كاليفورنيا، ونشرت في موقع "ساينتيفيك ريبورتس" الإلكتروني التابع لمجلة "نيتشر".
واستوحى الباحثون في عملهم من تقنية إعادة برمجة الخلايا التي توصّل إليها العالمان البريطاني شينيا ياماناكا والبريطاني جون غوردون الحائزان جائزة نوبل للطب عام 2012، والتي تقوم على تحويل خلايا بالغة إلى خلايا جذعية.
وتمكن الباحثون من إعادة برمجة خلايا جلدية عن طريق حقنها بمجموعة من الجينات الضرورية لتكوين الأمشاج.
وخلال شهر واحد، تحوّلت الخلية الجلدية إلى خلية منتجة للسائل المنوي أو البويضات، لكنها عقيمة.
وبحسب الباحثين، يحتاج السائل المنوي المنتج إلى مرحلة إنضاج ليصبح خصباً.
وقال الباحث كارلوس سيمون "ما زال المسار طويلاً جداً" وخصوصاً بسبب وجود عقبات قانونية أمام إنتاج أجنة بشرية بواسطة تقنية مماثلة، وهو ما تحظره مثلاً بريطانيا حيث يأمل الفريق بمواصلة الأبحاث.
تــابــــع كــل الأخــبـــــار.
إشترك بقناتنا على واتساب

Follow: Lebanon Debate News

الـــمــــزيــــــــــد
الـــمــــزيــــــــــد





